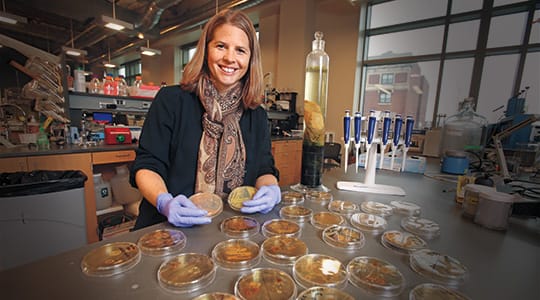

Marquette civil, construction and environmental engineering professor receives Way Klingler Young Scholars Award
August 22, 2017
MILWAUKEE — Dr. Brooke Mayer, assistant professor of civil, construction and environmental engineering, was recently named one of the 2017 Way Klingler Young Scholar Award recipients.
The award grants up to $32,000 to fund a one-semester sabbatical. Mayer plans to spend the semester as a visiting scholar at the School of Sustainable Engineering and the Built Environment at Arizona State University.
Mayer plans to train on laboratory protocols for microbes that she has not yet worked with in her own research program. "My goal is to implement these laboratory protocols in my own research lab at Marquette to broaden my research portfolio to encompass additional emerging pathogens," Mayer adds.
This award will also give Mayer the opportunity to work with a group of phosphorus recovery experts at ASU, including Dr. Bruce Rittmann and Dr. Treavor Boyer. Together, they will pursue new nutrient recovery research opportunities, including identifying and collaborating on research proposals and writing articles for peer reviewed journals.
The Way Klingler Young Scholar Awards support promising young scholars in critical stages of their careers with awards up to $32,000. The awards are intended to fund $2,000 in operating costs and to cover 50 percent of salary to afford the recipient a one-semester sabbatical.
# # #